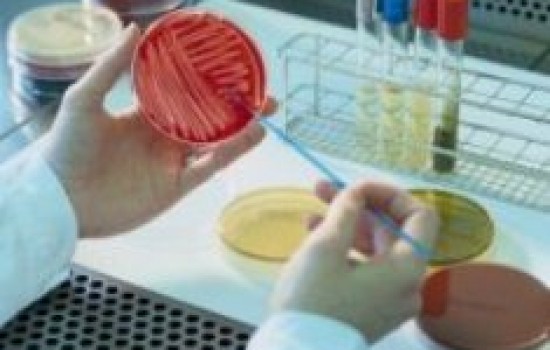

รีวิวทัศนมาตรศาสตร์ มหาวิทยาลัยนเรศวร
ภาควิชาทัศนมาตรศาสตร์ มหาวิทยาลัยนเรศวร อยู่ภายใต้การดูแลของคณะสหเวชศาสตร์ เปิดรับนิสิตรุ่นแรกในปีการศึกษา 2555 และผ่านการรับรองโดยคณะกรรมการประกอบโรคศิลปะเป็นที่เรียบร้อย
หลักสูตรทัศนมาตรศาสตรบัณฑิตที่นี่ เน้นด้านการฝึกทักษะของวิชาชีพให้กับน้องๆ นักศึกษา มีความร่วมมือกับสมาคมทัศนมาตรศาสตร์แห่งประเทศไทย ภาควิชาจักษุวิทยา คณะแพทยศาสตร์ มหาวิทยาลัยนเรศวร และผู้เชี่ยวชาญจากมหาวิทยาลัย Tubingen ประเทศเยอรมนี ที่มีความรู้ความสามารถร่วมเป็นอาจารย์ผู้สอนทั้งภาคทฤษฎี ภาคปฏิบัติ และการฝึกงานให้น้องๆ ด้วย
ในส่วนของสาขาวิชานี้มีค่าใช้จ่ายตลอดหลักสูตรเพียง 256, 000 บาท ถือว่าถูกที่สุดเมื่อเทียบกับหลักสูตรนี้จากที่อื่น ที่นี่จึงเป็นอีกทางเลือกหนึ่งให้น้องๆ ที่มีข้อจำกัดทางทุนทรัพย์และมีความสนใจในสาขานี้ได้เข้าเรียน
จุดเด่นของที่นี่ คืออะไร
- ได้รับปริญญา Doctor of Optometry, O.D. ของ มหาวิทยาลัยนเรศวร
- เป็นมหาวิทยาลัยที่ใหญ่ที่สุดในภาคเหนือตอนล่าง
- เคยเป็นวิทยาเขตของ มหาวิทยาลัยศรีนครินทรวิโรฒ
- ติด 1 ใน 13 มหาวิทยาลัยไทย จากการจัดอันดับมหาวิทยาลัยชั้นนำแห่งเอเชีย (QS University Rankings : Asia 2016)
เรียนเกี่ยวกับอะไร
ในเร็วๆ นี้จะมาการประกาศใช้พระราชกฤษฎีกาฉบับหนึ่ง กำหนดให้ร้านที่วัดสายตา ประกอบแว่น คอนแทคเลนส์ รวมทั้งเครื่องช่วยการมองเห็นต้องมีนักทัศนมาตรประจำ ทำหน้าที่ในการดูแลด้านระบบสายตา แก้ไขปัญหาสายตาสั้น ตาเข ตาเหล่ และคัดกรองโรคเกี่ยวกับดวงตาเบื้องต้น สามารถตรวจกล้ามเนื้อตา ฝึกกล้ามเนื้อตา ตรวจสายตาในงานเวชศาสตร์การกีฬา และปัญหาสายตาที่มาจากการทำงาน ในขณะที่กว่า 99% ของร้านเหล่านี้ยังไม่มีนักทัศนมาตรประจำอยู่เลย ร้านแว่นในประเทศไทยมี 6,000 - 8,000 ร้าน แต่มีนักทัศนมาตรที่มีใบประกอบวิชาชีพในประเทศไทยมีเพียง 88 คน อีกทั้งสาขาทัศนมาตรศาสตร์ ที่เป็นสาขาแพทย์ทางเลือกยังมีเปิดสอนเพียงไม่กี่แห่งในประเทศ และสิ่งที่นักทัศนมาตรแตกต่างออกไปจากจักษุแพทย์ คือ นักทัศนมาตรเป็นผู้เชี่ยวชาญเฉพาะทางด้านสายตา แต่ไม่ได้เกี่ยวข้องกับการผ่าตัด รักษาโรคที่เกี่ยวข้องทางกายภาพของตา เช่น โรคต้อหิน โรคต้อกระจก เป็นต้น อย่างไรก็ตามนักทัศนมาตรก็สามารถร่วมงานกับจักษุแพทย์ในโรงพยาบาลได้ด้วย
จบมาทำงานอะไร
นักทัศนมาตรในระบบราชการ , นักทัศนมาตรในโรงพยาบาล หรือคลินิกเอกชน ที่เกี่ยวข้องกับสายตา , โรงงานอุตสาหกรรมเลนส์สายตาและเลนส์สัมผัส , อาจารย์ผู้สอนในสถานศึกษาของรัฐและเอกชน , นักทัศนมาตรด้านแรงงานและการกิฬา , ผู้เชี่ยวชาญคลินิกทัศนมาตรศาสตร์เฉพาะทาง ฯลฯ
สมัครเรียนทำอย่างไร
ระบบรับตรง (กรกฎาคม-กันยายน)
- กำลังศึกษาอยู่ระดับชั้นม. 6 ของโรงเรียนในเขตพื้นที่ภาคเหนือ (เชียงราย, เชียงใหม่,
แม่ฮ่องสอน, ลำพูน, ลำปาง, พะเยา, น่าน, แพร่, กำแพงเพชร, ตาก, นครสวรรค์, พิจิตร, พิษณุโลก, เพชรบูรณ์, สุโขทัย, อุตรดิตถ์ และอุทัยธานี )
- มีผลคะแนน GAT/PAT2 (วิทยาศาสตร์)
- มีผลคะแนน O-NET ในวันที่มารายงานตัวเพื่อขึ้นทะเบียนเป็นนิสิตของมหาวิทยาลัย
- มีสุขภาพสมบูรณ์แข็งแรงและ ปราศจากโรค อาการของโรค หรือมีความพิการอันเป็นอุปสรรคต่อการศึกษา
- ไม่เป็นผู้ที่มีความพิการทางสายตา ดังนี้ ตาบอดทั้งสองข้าง , สายตาไม่ปกติ เมื่อรักษาโดยใช้แว่นแล้วยังมีสายตาต่ำกว่า 6/12 ทั้งสองข้าง , ตาบอดสีชนิดรุนแรงทั้งสองข้าง
แอดมิชชัน
- GPAX 20%
- O-NET 30%
- GAT 20%
- PAT2 (วิทยาศาสตร์) 30% ขึ้นไป
ค่าใช้จ่ายตลอดหลักสูตร
256, 000 บาท
รายละเอียดค่าใช้จ่าย
32, 000 บาท/เทอม
 ปริญญาตรี
ปริญญาตรี
 ปริญญาตรี
ปริญญาตรี

ทัศนมาตรศาสตร์
มหาวิทยาลัยนเรศวร
รีวิวทัศนมาตรศาสตร์ มหาวิทยาลัยนเรศวร
ภาควิชาทัศนมาตรศาสตร์ มหาวิทยาลัยนเรศวร อยู่ภายใต้การดูแลของคณะสหเวชศาสตร์ เปิดรับนิสิตรุ่นแรกในปีการศึกษา 2555 และผ่านการรับรองโดยคณะกรรมการประกอบโรคศิลปะเป็นที่เรียบร้อย
หลักสูตรทัศนมาตรศาสตรบัณฑิตที่นี่ เน้นด้านการฝึกทักษะของวิชาชีพให้กับน้องๆ นักศึกษา มีความร่วมมือกับสมาคมทัศนมาตรศาสตร์แห่งประเทศไทย ภาควิชาจักษุวิทยา คณะแพทยศาสตร์ มหาวิทยาลัยนเรศวร และผู้เชี่ยวชาญจากมหาวิทยาลัย Tubingen ประเทศเยอรมนี ที่มีความรู้ความสามารถร่วมเป็นอาจารย์ผู้สอนทั้งภาคทฤษฎี ภาคปฏิบัติ และการฝึกงานให้น้องๆ ด้วย
ในส่วนของสาขาวิชานี้มีค่าใช้จ่ายตลอดหลักสูตรเพียง 256, 000 บาท ถือว่าถูกที่สุดเมื่อเทียบกับหลักสูตรนี้จากที่อื่น ที่นี่จึงเป็นอีกทางเลือกหนึ่งให้น้องๆ ที่มีข้อจำกัดทางทุนทรัพย์และมีความสนใจในสาขานี้ได้เข้าเรียน
จุดเด่นของที่นี่ คืออะไร
- เป็นมหาวิทยาลัยที่ใหญ่ที่สุดในภาคเหนือตอนล่าง
- เคยเป็นวิทยาเขตของ มหาวิทยาลัยศรีนครินทรวิโรฒ
- ติด 1 ใน 13 มหาวิทยาลัยไทย จากการจัดอันดับมหาวิทยาลัยชั้นนำแห่งเอเชีย (QS University Rankings : Asia 2016)
เรียนเกี่ยวกับอะไร
จบมาทำงานอะไร
สมัครเรียนทำอย่างไร
- กำลังศึกษาอยู่ระดับชั้นม. 6 ของโรงเรียนในเขตพื้นที่ภาคเหนือ (เชียงราย, เชียงใหม่,
แม่ฮ่องสอน, ลำพูน, ลำปาง, พะเยา, น่าน, แพร่, กำแพงเพชร, ตาก, นครสวรรค์, พิจิตร, พิษณุโลก, เพชรบูรณ์, สุโขทัย, อุตรดิตถ์ และอุทัยธานี )
- มีผลคะแนน GAT/PAT2 (วิทยาศาสตร์)
- มีผลคะแนน O-NET ในวันที่มารายงานตัวเพื่อขึ้นทะเบียนเป็นนิสิตของมหาวิทยาลัย
- มีสุขภาพสมบูรณ์แข็งแรงและ ปราศจากโรค อาการของโรค หรือมีความพิการอันเป็นอุปสรรคต่อการศึกษา
- ไม่เป็นผู้ที่มีความพิการทางสายตา ดังนี้ ตาบอดทั้งสองข้าง , สายตาไม่ปกติ เมื่อรักษาโดยใช้แว่นแล้วยังมีสายตาต่ำกว่า 6/12 ทั้งสองข้าง , ตาบอดสีชนิดรุนแรงทั้งสองข้าง
แอดมิชชัน
- GPAX 20%
- O-NET 30%
- GAT 20%
- PAT2 (วิทยาศาสตร์) 30% ขึ้นไป
ค่าใช้จ่ายตลอดหลักสูตร
รายละเอียดค่าใช้จ่าย
ทัศนมาตรศาสตร์
มหาวิทยาลัยนเรศวร
เป็นนักทัศนมาตร ที่มีใบประกอบโรคศิลปะสาขาทัศนมาตรศาสตร์ สามารถประกอบวิชาชีพทาง ทัศนมาตรศาสตร์ (Optometry) ทัศนศาสตร์อุตสาหกรรม (Ophthalmic Industry) ทัศนวิทยาศาสตร์ (Vision Science) โดยสามารถตรวจ วัด วินิจฉัย ดูแลและฟื ้นฟู ความผิดปกติของการมองเห็น โดยกรรม วิธีการใช้แว่นตา เลนส์สัมผัส และการฝึกบริหารกล้ามเนื ้อตา โดยสามารถปฏิบัติงานในโรงพยาบาลต่างๆ ทั้งภาครัฐและเอกชน สถานพยาบาลที่เกี่ยวข้องทางสายตา ประกอบอาชีพส่วนตัวโดยเปิดสถานพยาบาล (คลินิกทัศนมาตร คลินิกสายตา ร้านตรวจวัดสายตาและร้านประกอบแว่นตา) สามารถเป็นผู้แทนจ าหน่าย น ้ายาและอุปกรณ์ทางการแพทย์ของบริษัทต่างๆ นักวิทยาศาสตร์การแพทย์ หรือนักวิทยาศาสตร์ เป็น นักวิจัยตามสถาบันอุดมศึกษาหรือสถาบันวิจัยต่างๆ หรือศึกษาต่อในระดับบัณฑิตศึกษา
วิเคราะห์ข้อมูลและประเมินคะแนน U-Review Score โดยฝ่ายวิชาการ upbean.com
หลักเกณฑ์การให้คะแนน
รายละเอียดคุณสมบัติ (Admissions)
- ระบบรับตรง (โควตา) มหาวิทยาลัยดำเนินการสอบคัดเลือกนักเรียนระดับชั้นมัธยมศึกษาปีที่ 6 ของโรงเรียนในเขตพื้นที่ภาคเหนือตอนล่าง คือ จังหวัดพิษณุโลก กำแพงเพชร ตาก นครสวรรค์ พิจิตร เพชรบูรณ์ สุโขทัย อุตรดิตถ์ และอุทัยธานี
รายละเอียดคุณสมบัติ (โควตาภาคเหนือ)
สามารถศึกษาต่อในระดับปริญญาโทและเอก ทั้งในประเทศและต่างประเทศได้หลายสาขาวิชา เช่น ทัศนมาตรศาสตร์ ชีวเวชศาสตร์ วิทยาศาสตร์แขนงต่างๆ เป็นต้น
5 รีวิว คะแนนความน่าสนใจจากผู้ใช้งาน 8.0 ดี
ทัศนมาตรศาสตร์ มหาวิทยาลัยนเรศวร ดีไหม?
เรียน6ปี นิสิตปี60 คือรุ่นที่6 การเรียนปีแรกก็เรียนเนื้อหา ม.ปลาย คนเก่งจะบอกว่าง่ายนะ แต่คนไม่เก่งแบบเรา เราว่ายากอะ อยู่ในคณะสหเวชศาสตร์ รับปีละประมาณ30เอง สาขาอื่นในคณะรับ60 สายงานก็ตามที่เจ้าของรีวิวบอกเลย อนาคตมันจำเป็นจริงๆนะ นักทัศนมาตร/หมอสายตา
กมลชนก
อยากรู้รายละเอียดการเรียน ว่าเรียนวิชาไรบ้าง อาจารย์สอนเป็นไง รุ่นนพี่จบมาทำงานที่ไหนกันบ้างครับ
รเณศ พรหมธาดา
ค่าเทอม 2 หมื่นนิดๆ ก็ถือว่าไม่แพงนะ แต่เรียนกี่ปีคะ เรียนอะไร มีคอนเนคกับที่ไหนเป็นพิเศษมั้ย จบมาเเล้วโอกาสในการทำงานเป็นไงบ้าง
จอมขวัญ ธันยธรณ์
GOOGLE MAP
ข้อมูลติดต่อ